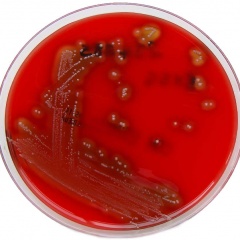

Al menos tres de los 118 casos de infecciones severas con Streptococcus pyogenes afectaron a pacientes pediátricos de Misiones y se atendieron en el Hospital Pediátrico de esta ciudad, según confirmó a PRIMERA EDICIÓN el presidente del Instituto de Previsión Social (IPS), el pediatra y cardiólogo infantil Lisandro Benmaor.
“En el Hospital Pediátrico de nuestra ciudad se registraron tres niños con infecciones más severas por Streptococcus pyogenes, pero por suerte, pese al potencial de gravedad, gracias a un diagnóstico rápido y tratamiento oportuno los tres pacientes evolucionaron muy bien”, indicó el profesional.
Según detalló, los casos en cuestión fueron de artritis (infección en articulación), neumonía (la infección se concentró en el pulmón) y shock tóxico “este último ocurre porque la bacteria puede producir una toxina que provoca un shock, que es la mala irrigación sanguínea de los órganos y tiene riesgo de muerte”, explicó.
Según recordó, estos 118 casos de infecciones severas por Streptococcus pyogenes detectados en Argentina en lo que va del año hasta el primer día de julio (que provocaron 17 muertos), “implican un aumento del 281% respecto a 2019”.
El aumento de estas infecciones severas es una tendencia que se está registrando en distintos países del mundo como Francia, Irlanda, los Países Bajos, Suecia y el Reino Unido de Gran Bretaña e Irlanda. Días atrás, el Reino Unido confirmó que la tasa de infección (en niños menores de 10 años) es superior a lo informado en los años anteriores a la pandemia de COVID-19 y sustancialmente más alta que en los últimos dos años.
En alerta, pero sin perder la calma
“Esto no significa que la gente tenga que ir a la guardia cada vez que le duela la garganta porque así explotarían las guardias pediátricas. Hay que dar pautas de control o alarma para saber cuándo es necesario consultar a una guardia y cuándo esperar la consulta con el médico en su consultorio”, destacó Benmaor.
Al respecto, indicó que “si el chico tiene regular estado general, la curva térmica no mejora, el dolor de garganta es creciente es importante hacer la consulta presencial al pediatra que, en los casos que corresponda, pedirá un hisopado de fauces para cultivo y así poder determinar si es un virus o una bacteria”.
Destacó además que es clave que la gente no se automedique y, para prevenir, es importante seguir las mismas pautas que con el COVID: lavado de manos, alcohol en gel, no estar con personas engripadas o con tos. “Esto no es una epidemia, un brote, pero sí hay una alerta de las sociedades de las entidades científicas argentinas como la Sociedad Argentina de Pediatría”, señaló.
Consultado sobre porqué esta bacteria que se aloja comúnmente en la garganta puede en algunos casos ingresar al torrente sanguíneo o colonizar órganos y generar cuadros severos, Benmaor señaló que “lo mismo ocurre con los virus, por ejemplo el de la gripe, en algunas personas ocasionan síntomas leves y en otras puede generar complicaciones, como una meningitis, gastroenteritis o una insuficiencia cardíaca como la miocarditis. El porqué a algunos les da una gripecita y a otros mandar a terapia intensiva… depende de la virulencia del germen y de las defensas del organismo”.
“Los pediatras conocemos al estreptococo muy bien porque es un germen que da angina, neumonía, otitis, también puede generar infecciones en piel, que pueden ser péptidos o fascitis necrotizante que ya es mucho más grave… y ahí puede pasar al shock tóxico que es potencialmente mortal”, señaló.
En este contexto, explicó que también pueden existir consecuencias posinmunes, porque el organismo se defiende del estreptococo y se autoataca provocando glomerulonefritis posestreptocócica o fiebre reumática, “cuando estudiaba medicina había un dicho que decía ‘la fiebre reumática lame las articulaciones y muerde el corazón’ porque genera una artritis reumatoidea y una cardiopatía reumática que es muy grave y puede requerir cirugía y hasta trasplantes cardíacos”.
Misiones no había notificado casos entre 2019 y 2022
El tratamiento adecuado contra una infección causada por la bacteria estreptococo es la penicilina que, “transcurridas las primeras 24 horas elimina la capacidad de propagación, permitiendo la reincorporación a las actividades habituales”, según indicaron desde el Ministerio de Salud de la Nación.
En raras ocasiones, la infección puede conducir a una enfermedad invasiva, potencialmente mortal, como fascitis necrosante, síndrome de shock tóxico estreptocócico y otras infecciones graves, así como enfermedades posinmunes, como glomerulonefritis posestreptocócica, fiebre reumática aguda y cardiopatía reumática.
La situación de en la provincia
Si bien Misiones no está entre las provincias con mayor cantidad de casos confirmados en 2023 acumulados hasta julio (Buenos Aires, Santa Fe, Chubut y Tierra del Fuego), sí tiene casos registrados. Además, está en el grupo de provincias junto a Catamarca, Neuquén, Salta, Santa Cruz, Tierra del Fuego y Tucumán que no habían tenido este tipo de infecciones severas en el período 2019-2022.
Según reportó Salud de Nación, los estadios clínicos que se presentaron con mayor frecuencia en los 118 casos reportados son: sepsis, shock séptico, celulitis y absceso.
En cuanto a la edad de los casos confirmados en el año 2023, la edad mínima fue 0 años y la máxima 83 años, con una mediana de 16 años. Del total de casos confirmados, 51 (43,2%) fueron menores de 10 años. En relación al sexo, se notificaron 50 casos de sexo legal femenino y 68 de sexo legal masculino.
En relación a los fallecidos con diagnóstico confirmado de infección invasiva por Streptococcus pyogenes, corresponden a pacientes de Buenos Aires, Chubut, Mendoza, Río Negro, San Luis, Santa Fe y Tierra del Fuego. Respecto de las edades de los casos fallecidos, se puede observar una mayor frecuencia en el grupo etario de 5 a 9 años, seguido del grupo de 65 a 69 años.
La bacteria no mutó
Los estudios y la vigilancia de laboratorio no revelaron nuevos linajes invasivos emergentes hasta la fecha, en Argentina tampoco hubo evidencia de circulación ni diseminación de los clones invasivos M1uk, emm 3 y emm 89 responsables de incremento repentino de enfermedad invasiva en los EEUU, Canadá, Reino Unido y Europa.